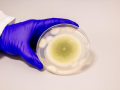
Researchers turn toxic fungus into potent anti-cancer compound - Hindi News | Researchers turn toxic fungus into potent anti-cancer compound | Latest health News at Lokmattimes.com

Kolkata, June 23 The parents of the junior woman doctor of state-run R.G. Kar Medical College & Hospital ... ...

![Body of Kerala nurse in Ahmedabad air crash identified, funeral tomorrow - Hindi News | Body of Kerala nurse in Ahmedabad air crash identified, funeral tomorrow | Latest health News at Lokmattimes.com Body of Kerala nurse in Ahmedabad air crash identified, funeral tomorrow - Hindi News | Body of Kerala nurse in Ahmedabad air crash identified, funeral tomorrow | Latest health News at Lokmattimes.com]()
Pathanamthitta (Kerala), June 23 The wait for the grieving family of Kerala nurse Renjitha Gopakumar, who was one ... ...
![Karnataka govt medical college teacher accused of sexually harassing student - Hindi News | Karnataka govt medical college teacher accused of sexually harassing student | Latest health News at Lokmattimes.com Karnataka govt medical college teacher accused of sexually harassing student - Hindi News | Karnataka govt medical college teacher accused of sexually harassing student | Latest health News at Lokmattimes.com]()
Shivamogga, (Karnataka), June 23 A female medical student on Monday lodged a sexual harassment case against an Assistant ... ...
![IDY 2025: 2,000 global events across 191 countries, 13 lakh pre-registrations on Yoga Portal - Hindi News | IDY 2025: 2,000 global events across 191 countries, 13 lakh pre-registrations on Yoga Portal | Latest health News at Lokmattimes.com IDY 2025: 2,000 global events across 191 countries, 13 lakh pre-registrations on Yoga Portal - Hindi News | IDY 2025: 2,000 global events across 191 countries, 13 lakh pre-registrations on Yoga Portal | Latest health News at Lokmattimes.com]()
New Delhi, June 23 Showcasing yoga's increasing global appeal and India's pivotal role in promoting holistic health and ... ...
![Former Kerala CM and veteran CPI-M leader V.S. Achuthanandan stable after suffering cardiac arrest - Hindi News | Former Kerala CM and veteran CPI-M leader V.S. Achuthanandan stable after suffering cardiac arrest | Latest health News at Lokmattimes.com Former Kerala CM and veteran CPI-M leader V.S. Achuthanandan stable after suffering cardiac arrest - Hindi News | Former Kerala CM and veteran CPI-M leader V.S. Achuthanandan stable after suffering cardiac arrest | Latest health News at Lokmattimes.com]()
Thiruvananthapuram, June 23 Veteran CPI-M leader and former Kerala Chief Minister V.S. Achuthanandan, on Monday, after suffering a ... ...
![Yoga, social interactions key highlights of INS Teg's Mauritius visit - Hindi News | Yoga, social interactions key highlights of INS Teg's Mauritius visit | Latest health News at Lokmattimes.com Yoga, social interactions key highlights of INS Teg's Mauritius visit - Hindi News | Yoga, social interactions key highlights of INS Teg's Mauritius visit | Latest health News at Lokmattimes.com]()
New Delhi, June 23 Apart from performing Yoga on the International Day of Yoga, professional, social, and cultural ... ...
![Researchers turn toxic fungus into potent anti-cancer compound - Hindi News | Researchers turn toxic fungus into potent anti-cancer compound | Latest health News at Lokmattimes.com Researchers turn toxic fungus into potent anti-cancer compound - Hindi News | Researchers turn toxic fungus into potent anti-cancer compound | Latest health News at Lokmattimes.com]()
New Delhi, June 23 A team of US researchers has turned a deadly fungus into a potent cancer-fighting ... ...
![Recycled plastics can harm hormone systems, metabolism: Study - Hindi News | Recycled plastics can harm hormone systems, metabolism: Study | Latest health News at Lokmattimes.com Recycled plastics can harm hormone systems, metabolism: Study - Hindi News | Recycled plastics can harm hormone systems, metabolism: Study | Latest health News at Lokmattimes.com]()
New Delhi, June 23 A new study on Monday warned that a single pellet of recycled plastic can ... ...
![Drink Turmeric Water Daily: 6 Powerful Health Benefits You Should Know - Hindi News | Drink Turmeric Water Daily: 6 Powerful Health Benefits You Should Know | Latest health News at Lokmattimes.com Drink Turmeric Water Daily: 6 Powerful Health Benefits You Should Know - Hindi News | Drink Turmeric Water Daily: 6 Powerful Health Benefits You Should Know | Latest health News at Lokmattimes.com]()
Turmeric is used in households to enhance the taste of different dishes. However, turmeric is not a spice that ... ...
![India’s herbal and ayurvedic OTC market set to outpace global growth: Report - Hindi News | India’s herbal and ayurvedic OTC market set to outpace global growth: Report | Latest health News at Lokmattimes.com India’s herbal and ayurvedic OTC market set to outpace global growth: Report - Hindi News | India’s herbal and ayurvedic OTC market set to outpace global growth: Report | Latest health News at Lokmattimes.com]()
New Delhi, June 23 India’s herbal and ayurvedic OTC (over the counter) market is expected to grow at ... ...